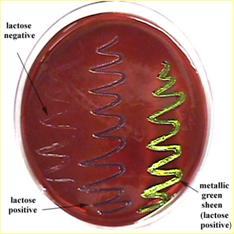
e coli on EMB.jpg

Microbiology Lab
Exercise 36:
Morphological Study of Unknown Bacterium
Exercise 37: Cultural
Characteristics
Exercise 47:
Bacteriological Examination of Water:
Qualitative Tests
REVIEW LAB RESULTS FROM LAST WEEK
Ex.
30: Ultraviolet Light: Lethal Effects
We will review the growth on the plates we started last week.
We will record our results as follows…
+++ substantial growth
++ moderate survival
+ 3 or fewer colonies survived
- no growth
Bacteria |
S.
aureus |
|||||||
|
Exposure Time |
10 sec. |
20 sec. |
40 sec. |
80 sec. |
2.5 min. |
5 min. |
10 min. |
20 min. |
|
Protection |
½ covered |
½ covered |
½ covered |
½ covered |
½ covered |
½ covered |
½ covered |
Petri dish lid |
|
Survival |
|
|
|
|
|
|
|
|
|
|
||||||||
|
Bacteria |
B.
megaterium |
|||||||
|
Exposure Time |
1 min. |
2 min. |
4 min. |
8 min. |
15 min. |
30 min. |
60 min. |
60 min. |
|
Protection |
½ covered |
½ covered |
½ covered |
½ covered |
½ covered |
½ covered |
½ covered |
Petri dish lid |
|
Survival |
|
|
|
|
|
|
|
|
Ex. 32:
Evaluation of Alcohol: Its
Effectiveness as an Antiseptic
Supplemental: Evaluation of Hand Sterilizers
Count the number of colonies that has grown in each of the
thumbprints and record them in the table below.
Calculate the percentage of reduction using the following formula…
Percent = (Colony count 1st press)
– (Colony count 2nd press)
X 100
Reduction (Colony
count 1st press)
(If the number of colonies has increased in the second
press, record a 0 in percent reduction.)
|
|
LEFT
THUMB (control = untreated) |
RIGHT
THUMB (treated) |
||||
|
|
Colony count 1st press (A) |
Colony count 2nd press (B) |
Percent Reduction |
Colony count 1st press (C) |
Colony count 2nd press (D) |
Percent Reduction |
|
Alcohol Immersion |
|
|
|
|
|
|
|
Alcohol Swab |
|
|
|
|
|
|
|
Hand Sanitizer |
|
|
|
|
|
|
Ex. 35: Effectiveness of Hand Scrubbing
Count the number of colonies
that has grown in each of the thumbprints and record them in the table
below.
|
|
CULTURE
COUNTS |
|||||||
|
|
1st press |
20 sec. |
2 min. |
4 min. |
6 min. |
8 min. |
10 min. |
12 min. |
|
Regular hand soap |
|
|
|
|
|
|
|
|
|
Anitbacterial hand soap |
|
|
|
|
|
|
|
|
|
Plain dish soap |
|
|
|
|
|
|
|
|
|
Antibacterial dish soap |
|
|
|
|
|
|
|
|
Do Antibacterial soaps provide better hand sanitation? ____________________
________________________________________________________________________________________________________________________________
Are they more useful in some situations than others? _____________________
________________________________________________________________________________________________________________________________
Ex. 36:
Morphological Study of Unknown Bacterium
Discussion:
When students are attempting to identify an unknown culture of bacteria, they must collect morphological and cultural characteristic data to assist them in using Bergey’s Manual.
The following steps would be performed…
First Period – from your assigned culture, you would inoculate 2 agar slants.
Second Period – after 24 hours of growth…
i. Record if your bacteria is Gram + or Gram -. Then determine the following…
1. Morphology – the shape of your bacteria (rod, coccus, etc.)
2. Arrangement (single, diplo, strepto, staphylo, etc.)
ii. If your bacteria is a Gram + rod, perform the following…
1. Spore stain – using nigrosine or India ink
a. check for spore formation. If it does form spores, your bacteria belongs either to the genus Bacillus, Clostridium, or Sporolactobacillus
2. Acid-fast stain – using an acid-fast staining kit
a. If your bacteria is acid-fast, it belongs to the genus Mycobacterium
i. Check for metachromatic granules
Ex. 37:
Cultural Characteristics
Supplies:
Assigned bacterial culture working stock
Petri agar dish
Agar slant
Agar deep
Nutrient broth
First period – inoculate media with bacterial culture working stock. Incubate for 24 hours.
Second period – record data about the following cultural characteristics…
i. Filiform – uniform growth along the line of inoculation
ii. Echinulate – Growth margins appear toothlike
iii. Beaded – separate colonies grow along the line of incoluation
iv. Effuse – Growth is thin, veil-like, and unusually spreading
v. Arborescent – branched, teethlike growth
vi. Rhizoid – rootlike appearance

i. Ring – grows in a ring around the margin of the test tube
ii. Pellicle – grows as a thick skin at the surface
iii. Flocculent – small masses are floating at the surface
iv. Membranous – grows as a thin skin at the surface

i. Turbid – cloudy growth
ii. Granular – small particles
iii. Flocculent – small masses
iv. Flaky – large particles
i. Granular – small particles
ii. Flocculent – small masses
iii. Flaky – large particles
iv. Viscid – sticky when prodded

Ex. 47:
Bacteriological Examination of Water:
Qualitative Tests
Discussion:
Water can contain large numbers of microorganisms & still be safe to drink (potable). However, waste water or sewage carried into rivers and lakes presents a serious problem. Such water can transmit a number of human pathogens which can cause severe gastrointestinal disease. NEVER assume that any water (even mountain streams) is free of fecal contamination. The consequences of such an assumption can be dire.
Water testing determines if a water supply has been contaminated with fecal material. The test uses members of the coliform (short, gram-negative rods, that don’t produce spores, & that ferment lactose to produce gas) group as indicator organisms of fecal contamination.
Good indicators have 3 qualities…
1) They are not usually found in soil in water (only where animals leave wastes)
2) They are easy to identify
3) They survive just longer than water borne pathogens
(An example of a good coliform indicator organism is Escherichia coli.)
Why don’t we just directly test for pathogens rather than for the indicator organism?
1) Pathogens are difficult (translate that into costly & time-consuming) to test for.
2) Pathogens are present in small numbers which makes them hard to detect.
Examples of water borne pathogens…
Salmonella typhosa, Shigella, Vibrio cholera, Giardia lamblia (Giardiasis), Hepatitis A, polio virus, etc.
Qualitative Test of Water:
Uses a 3
step process (Review the schematic below)

1)
Presumptive Test
· Tests to see if water contains lactose fermenting organisms
· Tests to see if those organisms also produce gas (which becomes trapped in Durham tube)
· Inoculate multiple test tubes (This produces a dilution series.)
o 5 – 10 ml water samples into test tubes containing DSLB (Double Strength Lactose Broth)
o 5 – 1 ml water samples into test tubes containing SSLB (Single Strength LB)
o 5 – 0.1 ml water samples into test tubes containing SSLB
· Positive tubes are those with large air bubbles trapped in the Durham tube
|
|
Pictures of postive,
doubtful, and negative results
|
·
o Calculate the most probable number (MPN) using the table below

· Water samples giving a positive or doubtful positive presumptive test should be subjected to the confirmed test.
2) Confirmed Test
· Streak an EMB plate from a positive tube (one that fermented lactose & produced a gas bubble) with the smallest inoculum of water in a manner that will give well-isolated colonies.
· A positive result is the growth of small, dark colonies (these are coliforms & they indicate contamination of the water with fecal material)
· Some of the colonies may have a green metallic sheen (this is characteristic of E. coli)
·
3) Completed Test
· Choose a typical colony from EMB & inoculate a lactose broth & a nutrient agar slant
· A positive result in the lactose broth is the formation of a gas bubble
· A positive result on the nutrient agar slant is obtained by performing a Gram stain and finding Gram negative, non spore-forming, short rods
· This verifies the results of the presumptive & confirmed tests.

Eosin Methylene Blue agar (EMB) – a selective and differential media
EMB complex inhibits gram positive bacteria, but allows gram negative organisms to grow. Therefore it is selective for gram negative bacteria (a characteristic of a coliform).
EMB allows lactose fermenting organisms to become pigmented (they become dark & may have a green, metallic sheen), but bacteria that don’t ferment lactose will be non pigmented. Thus, EMB is differential. You can literally tell by looking at the colony if it fermented lactose.